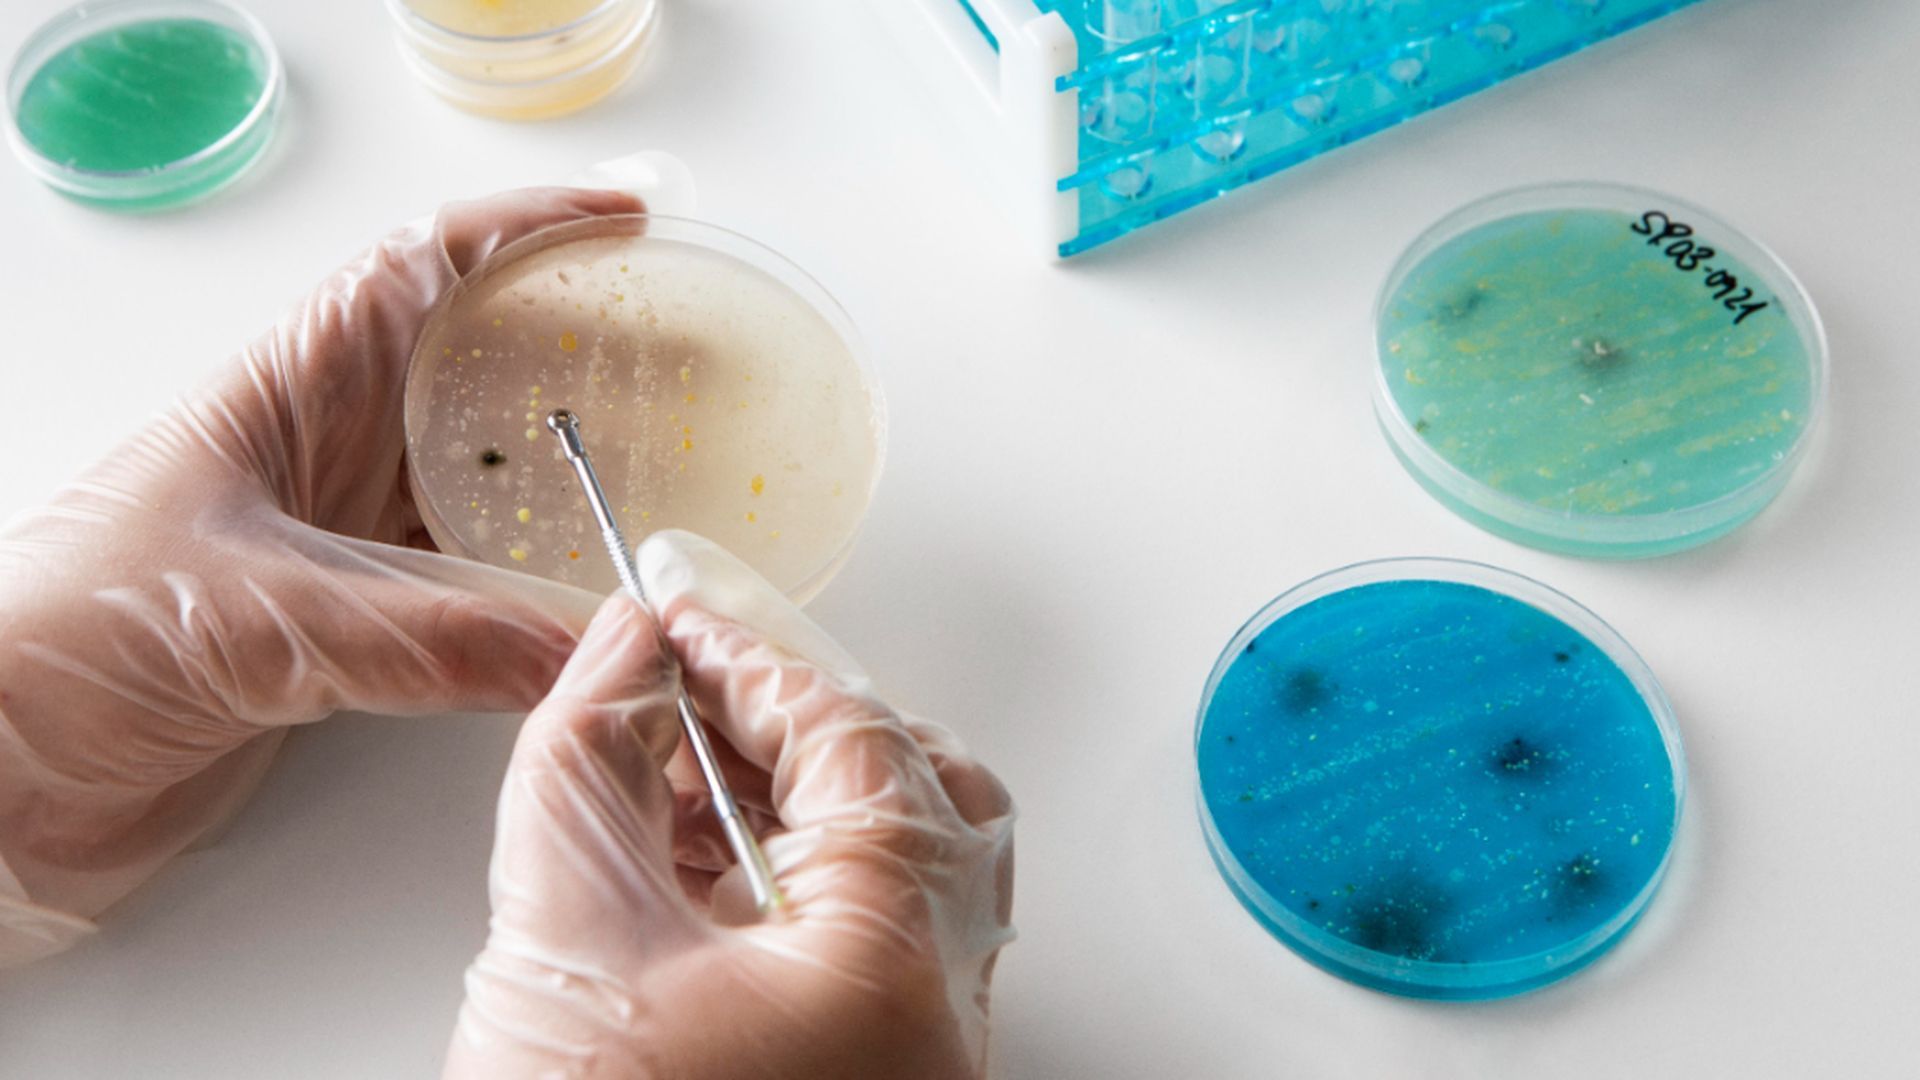
asocian_los_metales_pesados_con_las_patologias_cronicas.jpg asocian_los_metales_pesados_con_las_patologias_cronicas.jpg

La toxicidad de los metales pesados y su relación con las patologías crónicas
Mercurio, níquel, aluminio, estaño, plata y plomo son los metales más presentes
El mercurio está relacionado directamente con las enfermedades neurodegenerativas
Un reciente estudio presentado por el Hospital del Mar en Barcelona demuestra la presencia de metales pesados como cadmio, estroncio, talio o antimonio en la sangre del 70% de los habitantes de la ciudad condal. Junto a este, la Universidad de Granada, en un trabajo de 2020, encontró concentraciones de este tipo de materiales en el 51% de la población. Cualquier patología crónica está asociada "en mayor o menor grado" con un alto índice de toxicidad por metales pesados, una "contaminación silenciosa" que afecta a un muy elevado porcentaje de la población, ha asegurado en una entrevista con EFE el director de Biosalud Day Hospital, Mariano Bueno. Estos estudios no son algo aislado de España, sino que durante las primeras semanas de 2024 se han publicado decenas de estudios en distintos países que relacionan la presencia de plomo, arsénico o mercurio con enfermedades renales (en Italia), muerte de pacientes con EPOC (EEUU) o cáncer de próstata (Corea del Sur), entre otros.
Mercurio, níquel y aluminio entre los metales con más presencia
"En nuestro hospital hemos hecho nuestro propio estudio y es todavía peor: de 169 pacientes que acudieron con patologías crónicas, tenemos un 99 % de casos de toxicidad" por metales pesados y también por productos químicos y micotoxinas, lo que supone un porcentaje "abrumador", certifica el doctor Bueno. En el caso de los análisis practicados por esta clínica especializada en enfermedades crónicas, degenerativas e infecciosas, que cuenta con sedes en Madrid y Zaragoza, los metales descubiertos, por orden de importancia son mercurio, níquel, aluminio, estaño, plata y plomo "pero también otros en menor medida como el cadmio, el estroncio, el antimonio, el arsénico o el titanio".
¿Dónde están estos metales?
Con los datos recogidos ya han podido determinar "qué metales específicos producen algunas patologías concretas", como por ejemplo el mercurio, relacionado directamente con las enfermedades neurodegenerativas. "Es el más dañino de todos: intracelular, igual que el plomo, es un depresor inmunitario" y procede de diversas fuentes como las antiguas amalgamas de los empastes dentales, sustituidas hoy por otros materiales, o "los termómetros de toda la vida", aunque están siendo reemplazados también. Un mito en torno al mercurio alerta del supuesto daño por el consumo de pescado azul contaminado, pero para intoxicarse de esa manera hay que comer "cantidades industriales" de un pescado cuya ingesta es recomendable "en cualquier caso". "Es muy necesario porque es rico en omega 3", un provechoso ácido graso que ayuda a mantener el corazón sano y a fortalecer las neuronas, entre otros beneficios. Otro elemento especialmente insidioso es el aluminio que afecta sobre todo a los menores, "los niños nos vienen intoxicados por aluminio, pues las vacunas lo llevan como conservante", mientras que, en el caso de los adultos, la vía principal son los cosméticos, y no sólo las cremas de la cara, por ejemplo, sino también los desodorantes, que se administran en la axila, "donde existe un plexo vascular importante que facilita su absorción". El aluminio afecta al cerebro y genera "problemas cognitivos y, además, otras dolencias como la tendencia a desarrollar alergias", por lo que Bueno recomienda usar marcas que no lo incluyan entre sus ingredientes. Otros elementos penetran en el cuerpo vía implantes, como el titanio, presente en distintas prótesis, o vía alimentación, como el arsénico, que puede encontrarse "por ejemplo en el arroz procedente de países no europeos" que carecen de los controles sanitarios como los españoles
¿Es capaz el organismo de limpiarse?
El organismo humano "cada vez se muestra más incapaz de limpiarse por sí mismo de esas toxinas", por lo que es preciso recurrir a tratamientos especializados como el suero de quelación que porta unas sustancias que las "atrapa" para luego ser eliminadas mediante la orina. Sin embargo, en los últimos años disponen "de un sistema novedoso, la técnica denominada 'inuspheresis', que realiza una filtración directamente de la sangre del paciente, sin afectar a electrolitos u otros componentes necesarios" y permite eliminar no sólo los metales pesados sino los productos químicos, micotoxinas o exceso de colesterol. Esta terapia "es una maravilla que marca un antes y un después para tratar patologías crónicas", ha certificado Bueno.